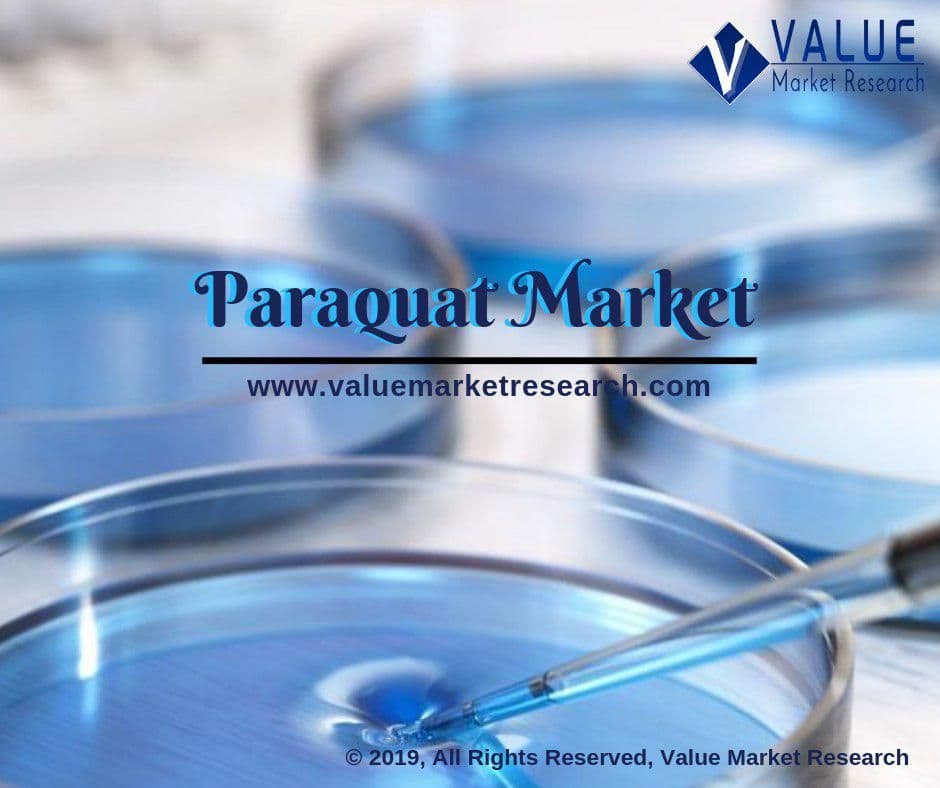

Paraquat Market Share | Research Report, 2028
Latest Paraquat Market Report published by Value Market Research, it provides a comprehensive market analysis which includes market size, share, value, growth, trends during forecast period 2021-2028 along with strategic development of the key player with their market share. Further, the market has been bifurcated into sub-segments with regional and country market with in-depth analysis.
Luba Chemical, Shandong Lufeng, Sinon Corporation, Solera, Syngenta, Willowood USA and Zhejiang Yongnong. An in-depth view of the competitive outlook includes future capacities, key mergers & acquisitions, financial overview, partnerships, collaborations, new product launches, new product developments and other developments with information in terms of H.Q.
Get more information on "Global Paraquat Market Research Report" by requesting FREE Sample Copy at: https://www.valuemarketresearch.com/contact/paraquat-market/download-sample
Market Dynamics
Growing global population followed by increasing global food demand is the prominent factor driving the market growth. Rising demand for better herbicides for better yield quality and quantity is again favoring the market growth. Owing to effective herbicide, crop desiccant and defoliant, paraquat has widened its application in agricultural purpose. However, ban imposed by EU nations and other developed countries on usage of paraquat owing to highly toxic to humans, is restraining the market growth.
This detailed market study is centered on the data obtained from multiple sources and is analyzed using numerous tools including porter’s five forces analysis, market attractiveness analysis and value chain analysis. These tools are employed to gain insights of the potential value of the market facilitating the business strategists with the latest growth opportunities. Additionally, these tools also provide a detailed analysis of each application/product segment in the global market of paraquat.
Browse Global Paraquat Market Research Report with detailed TOC at: https://www.valuemarketresearch.com/report/paraquat-market
Market Segmentation
The broad paraquat market has been sub-grouped into product and application. The report studies these subsets with respect to the geographical segmentation. The strategists can gain a detailed insight and devise appropriate strategies to target specific market. This detail will lead to a focused approach leading to identification of better opportunities.
By Product
· Aqueous Solution
· Soluble Granules
· Water Soluble Gel
· Others
By Application
· Farms
· Plantation
· Non-Agricultural Weed Control
· Others
Regional Analysis
Furthermore, the report comprises of the geographical segmentation, which mainly focuses on current and forecast demand for paraquat in North America, Europe, Asia Pacific, Latin America, and Middle East & Africa. The report further focuses on demand for individual application segments in all the regions.
Purchase complete Global Paraquat Market Research Report at: https://www.valuemarketresearch.com/contact/paraquat-market/buy-now
About Us:
Value Market Research was established with the vision to ease decision making and empower the strategists by providing them with holistic market information.
We facilitate clients with syndicate research reports and customized research reports on 25+ industries with global as well as regional coverage.
Contact:
Value Market Research
401/402, TFM, Nagras Road, Aundh, Pune-7.
Maharashtra, INDIA.
Tel: +1-888-294-1147
Email: sales@valuemarketresearch.com
Website: https://www.valuemarketresearch.com
Appreciate the creator